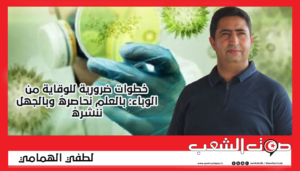

منذ بداية انتشار وباء الكورونا – كوفيد 19- لم يهدأ البشر في كافة أنحاء العالم. وعلى خلاف حرب البشر ضد البشر، والتي تتطلب صناعة وتوزيع وتنظيم الأسلحة وتوديع الأحبة ورفع رايات الحرب وإطلاق ثقافة مهاجمة العدوّ، سارعت الحكومات إلى إعلان الحجر الصحي العام وإعلان الطوارئ في المستشفيات.
وتحوّل القائد من الزيّ العسكري المعهود إلى الطبيب صاحب البدلة البيضاء والمزاج الهادئ. لقد تغيرت الأدوار، وهو ما يطرح علينا كبشر ردّة فعل واعية من أجل الانتصار وحماية ما أمكن من الأرواح، عبر اتخاذ جملة من الخطوات الضرورية:
أوّل خطوة للوقاية من هذا الوباء هي معرفة طبيعته، لكي نجيد التّصرّف إزاءه. وفي هذا الإطار برزت إجابتان، واحدة ذات مرجعية جاهلة مستندة إلى معارف معادية للطب، رغم تقدّم الإنسانية خلال القرنين الأخيرين، وهي مستمرة في الانتشار بين الناس. أمّا الإجابة الثانية فهي التي تقدّم لنا المعرفة العلمية وعلى رأسها المعرفة الصّحية والطبية، وهي التي أعلمتنا أنّ الكوفيد 19 هو فيروس يهاجم الجهاز التنفسي ويتناقل بين البشر عبر العدوى المباشرة وليس كما يروّج أصحاب الكسل الفكري والجهل بأنه “جند الله” وهو نقمة على الكافرين ورحمة للمؤمنين.
ثاني خطوة للوقاية من هذا الوباء تتمثل في كيفية التعامل معه بعد معرفة طبيعته.. فالإجابة الطبيّة هي الأساس الذي بمقتضاه وقع التركيز على النظافة ومنها بالأخص التعقيم وتحديد مسافة بين الأفراد ثم تركيز منظومة العزل الذاتي والعزل الإجباري والعزل الصحي العام. مقابل ذلك خرج علينا مُروّجو التّخلف والشّعوذة بمسيرات ليلية، ومثلهم لجأ إلى نشر “عقيدة القضاء والقدر” في غير محلّها ونزعوا عن الإنسان العقل والتدبير والتنظيم والوقاية والمجابهة والتخطيط والقدرة على تحويل المعركة من هجوم الفيروس إلى الحد منه والعمل على القضاء عليه. وبدل أن يستعملوا الجوامع في الدعوة الصريحة إلى الوقاية وإلى العزل الصّحي العام حاول أنفار منهم التّسلل إلى المساجد خلسة لإقامة صلاة الجماعة، وساهم آخرون في ممارسة التكالب على مصالحهم الأنانية والذاتية تارة بالجشع وتارة بالاحتكار. نحن التونسيون، من بيننا ملّة أظهروا وعيهم وإنسانيتهم العاليّة، ومنّا ملّة أظهرت بؤسها وقلّة حيائها واستثمارها في الخطر والانتهازية.
ثالث خطوة للوقاية من هذا الوباء، هو الانضباط التام للحجر الصحي العام حماية لذواتنا وللآخرين. فإن كانت الشجاعة زمن الحرب تستدعي الخروج، فإنّ الحرب ضدّ فيروس “الكورونا” المستجدّة تكمن في الالتزام الواعي بالسلوك الوقائي الذي أقرّه أهل الاختصاص. كما أنّ الحجر الصّحي لا يعني التصوّف القدري والانزواء البكائي والتذرّع النابع من الخوف والذعر والهلع. بل هو حجر صحي للتأقلم مع الفيروس والحد من انتشاره في الفضاء العام. الأمم الذكية هي الأمم التي تلجأ إلى العلم والمعرفة العلمية وتُكيّف سلوكياتها وفق المتطلبات. ما يتطلّبه الوضع اليوم هو التدرّب على وضعيات مشابهة تعرض لها الإنسان عبر تاريخه الطويل.
والأمم الذكية هي التي تجعل من علمائها قيادة للمجتمع لأنّ لديهم المعرفة المجهرية التي تغيب عن عامة الناس، إضافة إلى إدراكهم لكيفية التعاطي مع الوباء القاتل. للأسف الشديد وبعد ما يزيد عن الشهر الآن من إطلاق صيحة الفزع العام وما يقارب الخمسة عشر يوما من إعلان الحجر الصحي العام، ما يزال رهط صلب مجتمعنا، بما فيهم من هو في البرلمان، يتّخذون مرجعا لهم نظرية المؤامرة والدجالون باسم الدين، ونرى من هم ما يزالون يستخفون بأمر الوباء. الأمم الذّكية هي التي تجعل إمامها اليوم الطبيب ومرشدها الوصفة الوقائية ودواءها التكيّف مع الوضع الجديد والتدرب على نمط حياة يقضي على الفيروس المستجد.
لطفي الهمامي
صوت الشعب صوت الحقيقة
